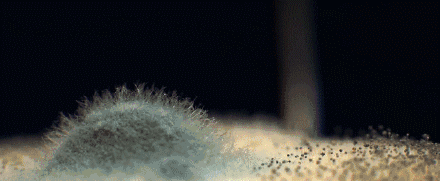
图片

女生,到了25岁以后,就特别在意自己的si处健康!
因为女性下面的“小妹妹”真的非常脆弱,很多小病往往就起源于一些微小的“信号”:比如有难闻异味、白带颜色不正常、瘙痒炎症……

小编之前就科普过:其实咱们”妹妹“有点味道也是正常的生理现象,千万别因此自卑。
但如果味道较严重或者分泌物异样,那肯定就是菌群失调,得注意了!
稍微好点是白带异常:呈脓性、发黄像豆腐渣一样,
动一动,那发酵的酸臭味就从下面直冲别人的鼻孔里..

如果放任不管,密密麻麻细菌越来越多,会带来更可怕的问题。

比如yin道炎,每次瘙痒肿痛还长小红包!
痒起来的时候让人坐卧不宁
开会、走路、地铁里
想抓又不方便,抓了又疼
分分钟想原地爆炸,灵魂出窍
还有交叉感染的性生活,
闷热不透气的内裤,
特容易导致尿路感染!!
每次尿尿都是揪心刺痛,甚至尿出血,
严重点必须去医院,
不停吃药后还是容易反复发作。

在咱们国内的很多女性还在用沐浴露(碱性 越洗越容易出问题)洗si处的时候,发达国家早已开始使用si处洗液。
据调查,她们不仅减少82%的妇科疾病,夫妻关系也更为暧昧亲密。

所以姑娘们
除了买大几千的护肤品保护脸蛋外
脆弱的秘密花园同样需要爱惜

为了唤醒大家对si处健康的重视,我们献身测评了市面上5款常见si处洗液!

有的颜值普通,用完以后反而会突然变痒,吓得马上停用。
有的太刺激,清凉感太强,穿着衣服别人都能闻到,很尴尬。
有的属于药字号,用力过猛反而破坏生态平衡。

最终选出一款大家都一见钟情的品牌 - 笙木之源女士沐浴凝露。
它的包装简约高级,一眼秒杀市面上所有“老旧丑”女性洗液!


为什么不直接叫si处洗液?
就是因为品牌方非常贴心的站在中国女性心理角度考虑,斩断客人亲戚来家后看到的遐想议论。(真的非常暖!)

品牌方还联合瑞士巨头集团 - 奇华顿(跟迪奥,香奈儿、祖马龙都是有合作)的联合定制香型。
那味道仿佛误入雨后森林,清爽鲜花和原木混合在一起,淡雅轻奢,沁揉在肉体上,仿佛喷了si处香水!
好多姑娘说用了它以后,晚上前戏时常多了一倍。

我还发现原来很多时尚博主早已开始分享:
“姨妈期妹妹味道减轻很多,也不怎么瘙痒了“
”性生活一定要和男友一起洗,杜绝好多妇科病!“
”洗完后感觉清清爽爽很酥服~“
”效果很明显!酸臭味消失,人都活过来了。“

还有很多成熟的姐妹也早已学会保护自己~
大家都知道日本性文化开放,对si处护理的重视更走在世界前端。
所以笙木之源选择联合日本秀一化妆品株式会社,一同研发了这款女士沐浴凝露(用于si处)。
整体研发共计20名科学家,其中最重磅的两位研发者,分别是:

ROBERT BAO HA首席科学家,他被誉为配方界的“一代宗师”,获得过10项美国专利!
日本东京工业大学博士付子华,他曾任宝洁技术总监、联合丽华全球总监,多次荣获全球技术创新等技术大奖。

两位强强联合,在si处护理的安全和功效上,可以格外放心。
首先成分里萃取了3大抑菌王牌植物:
互生叶白千层叶油
艾叶提取物
库拉索芦荟叶水
它们能杀灭多种病菌和病原体的发育繁殖,达到干净的生态环境,降低异物生长可能性。
检测结果显示它们针对妇科病的三大巨头有害菌,最高抑菌率能达98%!
从此能避免许多异味瘙痒的痛苦场景!

以前偶尔也会有瘙痒异味的我,现在每天都很舒适自在。
、
除此之外,它还像一款si处抗衰面霜,
带着我们从未细心保养过的”妹妹“重返粉嫩少女肌。
里面添加了胜肽、燕麦肽等多种高端奢侈成分,据研究表明效果堪比肉毒杆菌,小棕瓶、olay、院线产品都在用它们。
它能穿过角质层间隙进入到真皮内,让暗沉萎靡的”妹妹“重获粉嫩春天。
也可以用于身体暗沉发黑的部位。
想要那里白嫩就搓揉那里,毕竟白白嫩嫩的自己看着也满心欢喜。

市面上普遍2D玻尿酸,但它添加的是4D玻尿酸,
精准定位皮肤的表面、角质层、表皮层、真皮层,瞬时给干涸的妹妹喝饱水~

不信你看实验,在手上使用后并不会带走原有水分使其干燥,反而提升了一倍滋养。

还添加了了胶原蛋白和维生素E,让”妹妹“更为紧致弹性。
凭借一己之力,改善情侣夫妻的生活和谐~
经期是妇女炎症的高发期,免疫力下降,卫生巾的使用让有害细菌加倍滋生。
此刻就特别容易外阴瘙痒,而且那里敏感脆弱,一抓就容易破,结果又痛又痒,难受到爆炸!
笙木之源除日常款,还专为女孩们生理期定制了清爽款。
清爽款基于日常款基础上添加乳酸杆益菌,平衡紊乱菌群,帮助消除血腥异味,加上保护罩。

洗掉被姨妈巾闷了一天的血渍,给“妹妹”一个放空的机会。
敏感肌都可放心使用,洗完后姨妈期的黏腻统统消失,超舒服!

它成分无色素添加,呈透明啫喱状,1泵不多不少,刚好使用一次。

经检测PH值≈5.5,弱酸性符合女性si处的生态环境,达到温和不刺激的效果。
拥有非常细腻绵密的泡泡,能穿透秘密森林完美覆盖si处每个角度,带走有害菌种。
官方检测其安全程度均为合格,不论是给娇贵的孕妇,还是给小朋友洗pp均可使用。
女生一定要爱惜自己!
时刻关注si处健康状态,并没有没有好羞耻的,如果当下护理不及时,以后几千元医药费就更难受了。
用了它的女性更是打破了心理障碍,跟对象的鱼水之欢更为开放享受~

像这样一瓶200ML的笙木之源女士沐浴凝露,
一周使用2~3次即可提前预防80%的女性妇科疾病。

一次1泵,日常款搭配清爽款,足足可用500多天(一年多)!!
如果你的闺蜜、母亲也在遭受不间断的妇科病折磨,不妨把文章转发给她看看,提高中国女性si处健康预防,从我做起。